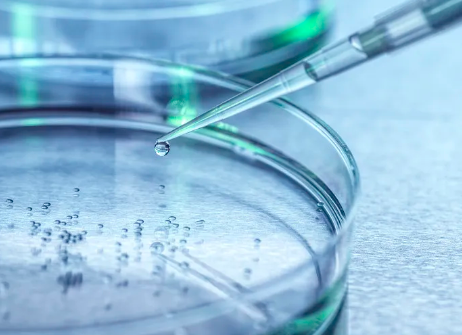
image.png

青海如何利用培養(yǎng)干細胞實現(xiàn)醫(yī)療突破,有哪些實際作用
2024-11-07 14:31:01 來源: 小編 咨詢醫(yī)生
隨著醫(yī)學(xué)科技的迅猛發(fā)展,干細胞研究越來越受到關(guān)注,而青海省在這一領(lǐng)域也逐漸展示出其獨特的潛力。通過引進先進的干細胞培養(yǎng)技術(shù)和研究理念,青海正在努力實現(xiàn)醫(yī)療領(lǐng)域的重大突破,本文將探討這一過程及其實際應(yīng)用。
一、青海干細胞研究的背景
青海省地處青藏高原,具有獨特的地理環(huán)境和豐富的生物資源,這為干細胞研究提供了良好的條件。同時,隨著國家對生物醫(yī)藥產(chǎn)業(yè)的重視,青海也開始加大對干細胞技術(shù)的投入,推動相關(guān)科研項目的實施。
二、干細胞的基本知識與分類
干細胞是指在特定條件下能自我更新并分化為多種類型細胞的細胞。根據(jù)其來源,干細胞主要分為:
1.胚胎干細胞:來源于早期胚胎,具有很強的分化潛能。
2.成人干細胞:存在于成人各類組織中,主要用于組織修復(fù)與再生。
3.誘導(dǎo)多能干細胞(iPSC):通過基因重編程將成體細胞轉(zhuǎn)化為具有多能性的干細胞。
在青海的研究中,成人干細胞和誘導(dǎo)多能干細胞的應(yīng)用尤為突出。
三、青海在干細胞研究中的醫(yī)療突破
1.再生醫(yī)學(xué)的應(yīng)用
青海的干細胞研究在再生醫(yī)學(xué)中展現(xiàn)出巨大的應(yīng)用潛力。利用干細胞的特性,科研人員可以在實驗室中培養(yǎng)出不同類型的細胞,用于修復(fù)組織損傷。這在治療心臟病、糖尿病、肝病等慢性病上具有重要意義。
2.免疫治療的新方向
干細胞不僅可以用于組織再生,還在免疫治療方面顯示出良好的效果。青海的研究團隊正在探索用干細胞修復(fù)受損的免疫系統(tǒng),這對于癌癥及自身免疫疾病的治療可能帶來革命性的進展。
3.藥物篩選與毒性測試
在新藥研發(fā)的過程中,干細胞能夠用于藥物篩選和毒性測試。青海的科研機構(gòu)與制藥公司合作,利用人類干細胞模型進行藥物的初步篩選,從而提高新藥研發(fā)的效率和安全性。
四、青海干細胞研究面臨的挑戰(zhàn)
盡管青海在干細胞研究中已經(jīng)取得了一系列進展,但仍面臨一些挑戰(zhàn):
1.技術(shù)瓶頸:干細胞的培養(yǎng)和分化過程復(fù)雜,需要更高的技術(shù)水平和設(shè)備支持。
2.倫理問題:部分研究涉及胚胎干細胞,可能面臨倫理審查的限制。
3.資金投入:科研需要持續(xù)的資金投入,青海需要進一步吸引投資與支持。
五、展望未來
青海在干細胞研究及應(yīng)用領(lǐng)域的發(fā)展前景廣闊。隨著政府**的支持和科研經(jīng)費的增加,青海有望成為全國干細胞研究的重要基地。此外,通過加強與國內(nèi)外科研機構(gòu)的合作,青??梢栽诟杉毎夹g(shù)方面取得更大突破,為疾病的治療提供新的解決方案。
干細胞技術(shù)作為一項前沿醫(yī)學(xué)技術(shù),正在青海省的醫(yī)療領(lǐng)域中發(fā)揮越來越重要的作用。通過不斷的研究與實踐,青海有望在再生醫(yī)學(xué)、免疫治療等方面取得新的進展,為患者帶來福音。未來,青海的干細胞研究不僅將推動當?shù)蒯t(yī)療水平的提高,也為全國的生物醫(yī)學(xué)發(fā)展作出積極貢獻。
- 2024-09-27貝拉醫(yī)院介紹資料
- 2024-10-14干細胞超低溫樣本庫生產(chǎn)商
- 2024-09-06干細胞技術(shù)和制劑的區(qū)別和聯(lián)系
- 2024-11-12干細胞多肽產(chǎn)品有哪些功效,作用如何
- 2024-10-25干細胞的八大功效與劑型選擇指南?
- 2024-10-19濰坊哪家干細胞捐贈機構(gòu)值得信賴?
- 2024-08-30干細胞移植是骨髓移植嗎,附具體操作流程
- 2024-08-12干細胞治療視網(wǎng)膜色素變性的原理
- 2024-08-23什么是造血干細胞移植,移植流程步驟解讀
- 2024-08-22干細胞移植的副作用,干細胞移植利弊
- 2024-09-09中華干細胞國際研究中心怎么樣,本文詳細介紹
- 2024-10-11干細胞抗衰老的費用是多少?性價比如何?
- 2024-10-04干細胞國家認可機構(gòu)名單公布:如何找到權(quán)威認證的機構(gòu)?
- 2024-08-10干細胞修復(fù)疤痕費用,干細胞祛疤效果怎么樣
- 2024-07-21干細胞有什么作用,干細胞作用效果怎么樣
- 2024-09-06牙齒干細胞存儲有什么作用,存儲費用多少
- 2024-09-27廣州貝拉國際慢性醫(yī)療中心
- 2024-09-03干細胞技術(shù)服務(wù)需要資質(zhì)嗎,國內(nèi)有資質(zhì)的干細胞生產(chǎn)機構(gòu)
